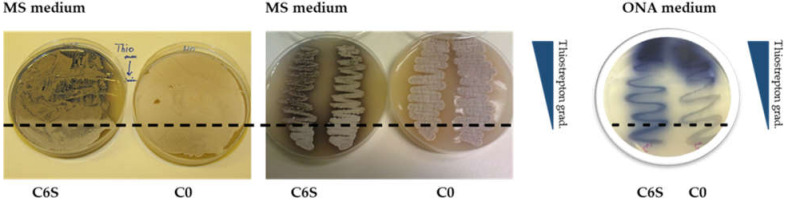
Figure 6

Abstract
Regulatory RNAs control a number of physiological processes in bacterial cells. Here we report on a 6S-like RNA transcript (scr3559) that affects both development and antibiotic production in Streptomyces coelicolor. Its expression is enhanced during the transition to stationary phase. Strains that over-expressed the scr3559 gene region exhibited a shortened exponential growth phase in comparison with a control strain; accelerated aerial mycelium formation and spore maturation; alongside an elevated production of actinorhodin and undecylprodigiosin. These observations were supported by LC-MS analyses of other produced metabolites, including: germicidins, desferrioxamines, and coelimycin. A subsequent microarray differential analysis revealed increased expression of genes associated with the described morphological and physiological changes. Structural and functional similarities between the scr3559 transcript and 6S RNA, and its possible employment in regulating secondary metabolite production are discussed.
Keywords: small RNA, 6S RNA, Streptomyces, antibiotics, secondary metabolism
1. Introduction
Streptomycetes are Gram-positive soil-dwelling bacteria. The soil niche represents a harsh living environment where the natural microbial inhabitants have evolved various nutrient-acquiring and life-defending strategies. Streptomyces have a complex developmental life cycle that begins with germinating spores. They then form branching vegetative hyphae that differentiate into aerial mycelium and spores again [1,2,3,4]. Moreover, the streptomycetes possess extraordinary genetic equipment for sensing extracellular signals and producing various specialized metabolites [5]. Among other applications, these molecules encompass over two-thirds of the clinically useful antibiotics and other compounds of industrial value [6]. The developmental complexity and antibiotic biosynthesis of these organisms require a complex regulatory network, which is responsible for addressing proper responses to changes in environmental conditions [7].
In order to achieve such responses, a number of pleiotropic regulators are involved in the gene expression control of the streptomycetes. So-called regulatory RNAs represent one such regulatory sphere. A single RNA molecule may regulate multiple genes, thus broadly influencing the physiology of the cell [8]. These RNAs act either simply by base-pairing with target nucleotides, or by binding target proteins via their secondary structures. 6S RNA achieves gene regulation using the second strategy and is one of the best studied regulatory RNAs in bacteria [9]. 6S RNA has a direct influence on the transition between developmental stages thanks to its direct association with the sigma70-RNA polymerase holoenzymes (RNAP-HrdB in Streptomyces). The formation of such complexes interferes with exponential phase-specific transcription [10,11,12]. Due to its function, the promoter-like secondary structure of 6S RNA is highly conserved across the bacterial kingdom. This high degree of conservation has enabled the identification of more than 100 potential 6S RNA homologues in diverse eubacterial species, using computational searches [13]. Notably, however, Streptomyces were absent among those species in which 6S RNA was identified.
We had developed a bioinformatic tool that detected two streptomycete 6S-like transcripts whose secondary structures exhibited convincing similarity with those of 6S RNAs found in other bacteria [14,15]. Subsequently, it was shown that a null mutation of one of these genes (scr3559), affected actinorhodin production in S. coelicolor [16]. To analyze the effect of the scr3559 RNA on cell morphology and physiology, we constructed a strain that over-expresses scr3559, with its gene placed under the control of a thiostrepton-inducible promoter. Interestingly, the levels of the scr3559 RNA were consistent with a strong effect on the exponential growth of S. coelicolor, as well as on its secondary metabolite production. This suggests that the scr3559 RNA functions as an important developmental regulator.
2. Materials and Methods
2.1. Strains, Media and Conditions of Cultivation
Streptomyces coelicolor M145 was used as a model wild type strain, as well as the parental strain used to construct a strain that over-expresses the scr3559 gene. The resulting S. coelicolor strains, Escherichia coli strains, and all plasmids/cosmids used in this study are summarized in Table 1.
Table 1.
Bacterial strains and plasmids used in this study.
| Strain or Plasmid | Genotype, Description or Use | Reference or Source |
|---|---|---|
| S. coelicolor | ||
| M145 | SCP1− SCP2− | [18] |
| C6S | scr3559 over-expression: in order to be expressed from the tipA promoter, the scr3559 gene was cloned into the high copy number plasmid pCJW93. | This work |
| C0 | a control strain containing an empty pCJW93 vector | This work |
| E. coli | ||
| DH5α | Plasmid construction and general subcloning | Invitrogen |
| ET12567/pUZ8002 | Generation of methylation-free plasmid DNA and conjugation from E. coli into S. coelicolor | [20] |
| Plasmids/cosmids | ||
| pIJ2925 | General cloning vector | [21] |
| pCJW93 | High-copy-number E. coli/Streptomyces plasmid containing a thiostrepton inducible (tipA) promoter | [22] |
| StH5 | S. coelicolor cosmid containing the scr3559 gene | [23] |
E. coli strains were grown at 37 °C on solid agar and in LB liquid medium [17]. Streptomyces strains (108 spores) were grown at 30 °C on the solid agar media soya flour-mannitol (MS), supplemented minimal (SMMS) [18], and Oxoid Nutrient Agar (ONA, OXOID CZ s.r.o, Thermo Fisher Scientific, Brno, Czech Republic) or in liquid rich with glucose, unless otherwise stated, media (R3) [19] or minimal NMMP [18].
2.2. Construction of High-Copy-Number Vector Overexpression Strains
The over-expression strain used in this study was constructed using the actinomycete high-copy-number shuttle vector pCJW93 (Table 1). The scr3559 gene from S. coelicolor was PCR amplified from cosmid StH5 (Table 1) using primers 6SO/E1 (GTGCGCGCCTGTCCGCGCTTG) and 6SO/E2 (GCCGATCGGTCGTCGGTTCGC), and the product was inserted into pIJ2925 (Table 1) using a rapid DNA ligation kit (Roche, Merck Life Science spol. s r.o., Prague, Czech Republic). The construct was transformed into DH5α E. coli cells (Table 1). The scr3559-containing fragment was cut out from the plasmid with BglII and subcloned into the BamHI site of the over-expression vector pCJW93, downstream from the thiostrepton-inducible (tipA) promoter. The plasmid was passaged through the non-methylating E. coli strain ET12567/pUZ8002 (Table 1) before being introduced into S. coelicolor M145 by conjugation [18], resulting in the construction of the C6S over-expression strain. A control strain, C0, containing the pCJW93 vector lacking any insert was constructed simultaneously.
2.3. Mapping of 5′ Ends
The 5′ rapid amplification of cDNA ends (5′ RACE) was performed using the FirstChoice® RLM RACE kit (Invitrogen, Thermo Fisher Scientific, Brno, Czech Republic) with minor modifications, as described in [24]. Total RNA was extracted from a plasmid-free strain of S. coelicolor that had been cultivated for 72 h in NMMP liquid medium.
RNA quality was assessed by determining the RNA-integrity number (RIN) and only those samples with a RIN higher than 7 were further analyzed. Ten micrograms of RNA were treated with tobacco acid pyrophosphatase (TAP) before being ligated to a 5′ RACE adapter using T4 RNA ligase. The obtained product was used as template for reverse transcription using 50 µM of random decamers and M-MLV reverse transcriptase.
The resulting cDNA served as a template for 5′ end PCR amplification using an outer adaptor-specific oligonucleotide and an oligonucleotide complementary to the scr3559 RNA sequence (CGCTTACTCGGGACCGGT). The PCR product was used as a template for a second PCR reaction using an inner adaptor-specific oligonucleotide and an inner ‘nested’ scr3559 RNA-complementary primer (6SR; ACCGGTATACAAAGGACTCAACGG). The second PCR product was separated on an agarose gel and eluted using the QIAquick-Gel Extraction kit (Qiagen, GeneTiCA s.r.o., Prague, Czech Republic). The purified products were cloned into the TOPO® vector using TOPO TA Cloning® (Invitrogen) and transformed into TOP10F competent cells (Invitrogen). Plasmid DNA was extracted from cells containing cDNA inserts using the QIAprep® Miniprep kit (Qiagen), and the cloned inserts were sequenced using M13 primers.
2.4. Differential Expression Analyses (Northern Blot)
At indicated time points of cultivation in the NMMP liquid medium (with thiostrepton supplemented at 50 µg/mL), cells were harvested and RNA was isolated as described in [25]. UV spectroscopy and agarose gel electrophoresis were used to assess the quantity and quality of total RNA samples. Total RNA samples were separated on 6% denaturing polyacrylamide gels and were transferred to nylon membranes (BioRad s.r.o., Prague, Czech Republic) using a Trans-Blot semi-dry transfer cell (BioRad) (25 V, 4 °C overnight). The membrane was then UV-cross linked before being hybridized with the 5′-end-labeled oligonucleotide 6SR (ACCGGTAGTACAAAGGACTCAACGG), which corresponded to an internal segment of the scr3559 RNA. The hybridization was performed overnight at 42 °C in ULTRA hybridization buffer (Invitrogen). The detection and quantification of signals were conducted using a phosphorimager (BioRad).
2.5. Secondary Metabolite Production Assays
To quantify the actinorhodin and undecylprodigiosin levels in the C6S strain relative to the C0 strain, 108 spores of each were inoculated into NMMP liquid medium (with thiostrepton supplemented at 50 µg/mL). Cultures were shaken at 30 °C and samples were taken after 48, 72, and 144 h (unless otherwise stated). Actinorhodin and undecylprodigiosin levels were then quantified as described [26] and amounts were normalized per cell concentration.
2.6. Liquid Chromatography-Mass Spectrometry (LC-MS) Assay
Both C0 and C6S strains were cultivated for 48 h in R3 medium containing thiostrepton (50 µg/mL). Secondary metabolites were extracted from the culture supernatants using solid phase extraction [27,28]. LC-MS analyses were performed on the Acquity UPLC system with 2996 PDA detection system (194–600 nm) connected to LCT premier XE time-of-flight mass spectrometer (Waters Gesellschaft m.b.H., Prague, Czech Republic). Five microliters of the sample were loaded onto the Acquity UPLC BEH C18 LC column (50 mm × 2.1 mm I.D., particle size 1.7 μm, Waters) at 40 °C and eluted with a two-component mobile phase, A and B, consisting of 0.1% formic acid and acetonitrile, respectively, at the flow rate of 0.4 mL min−1.
The analyses were performed under a linear gradient program (min/%B) 0/5; 1.5/5; 15/70; 18/99 followed by a 1.0-min column clean-up (99% B) and 1.5-min equilibration (5% B). The mass spectrometer was operated in the positive “W” mode with capillary voltage set at +2800 V, cone voltage +40 V, desolvation gas temperature, 350 °C; ion source block temperature, 120 °C; cone gas flow, 50 L h−1; desolvation gas flow, 800 L h−1; scan time of 0.15 s; inter-scan delay of 0.01 s. The mass accuracy was kept below 6 ppm using lock spray technology, with leucine enkephalin being used as the reference compound (2 ng μL−1, 5 μL min−1). MS chromatograms were extracted for [M + H]+ ions with the tolerance window of 0.03 Da, smoothed with a mean smoothing method (window size; 4 scans, number of smooths, 2). The data were processed by MassLynx V4.1 (Waters).
2.7. Microarrays
Cultivation of the C6S and control C0 strains was performed in duplicate. 108 spores were inoculated into NMMP liquid medium (with thiostrepton at 50 µg/mL) and shaken at 30 °C. Cells were harvested after 72 and 144 h and the quality of the isolated RNA samples was determined by their RIN. Only those samples whose RIN was >7 were sent to the Oxford Gene Technology Company (OGT, Oxford, United Kingdom), where microarray analysis was performed as follows: the RNA samples were used as template for reverse transcription using random hexamer primers and Cy3/Cy5 dyes (swapped in the duplicates); the labeled cDNAs were hybridized on microarray slides containing 4 × 44,000 spotted oligonucleotides, mapped preferentially to the ORFs of the S. coelicolor genome. The differential expression was estimated using the binary logarithm of the ratio of the expression level in the test C6S sample to the level of expression in the control C0 sample.
3. Results
3.1. Size and Gene Position of the scr3559 Transcript
The scr3559 RNA (also called Sc2 in [15] or 6S RNA in [16]) is a 192 nt long transcript that folds into a 6S-like secondary structure [16]. Its gene is located between SCO3558 and SCO3559. It is noteworthy that it is oriented downstream of SCO3559, as illustrated here in Figure 1 (minus strand) and is in accordance with the RNA sequence shown in both the above-mentioned publications, although the gene is mistakenly depicted in the opposite direction in Mikulík et al. [16], where it is dubbed ssrS.
Figure 1.
Revised scr3559 gene orientation, relative to its flanking genes.
To precisely map the scr3559 transcription start site, a RACE experiment was performed using internal nested primers complementary to the scr3559 RNA. Two RT-PCR products were detected and sequenced (Figure 2). These corresponded to a nascent (pre-scr3559 RNA) and a processed transcript (scr3559 RNA) of sizes 260 and 192 bases, respectively. The transcription start site is thus located at genome position 3934888, whereas the processed 6S-like form, as presented previously, begins at position 3934820. Based on these results, secondary structures of precursor (pre-scr3559 RNA), processed (scr3559 RNA) and excised transcripts were modeled using the RNAfold algorithm (http://rna.tbi.univie.ac.at/cgi-bin/RNAWebSuite/RNAfold.cgi, accessed on 1 September 2021) [29] (Figure 2b).
Figure 2.
(a) 5′ RACE analysis. From the left: lanes 1–3 PCR products from the RACE experiment, taken from 72, 144, and 168-h-old cultures; lanes 4–5 RTase-free and ligase-free negative controls (no signals). The arrows point to those PCR products whose sequences correspond to the nascent scr3559 RNA (260 bases) and to the processed form (192 bases). The molecular sizes of the RACE-generated PCR products roughly corresponded to the sizes of the whole transcripts. (b) Secondary structure predictions for the 260 nt pre-scr3559 RNA, a processed 192 nt form and the excised 68 nt transcript. The structures were modeled using RNAfold software with energy parameters scaled to 30 °C. The scissors mark the predicted site of cleavage in the precursor transcript. The green and blue clouds indicate the 5′ and 3′ ends of scr3559 RNA, respectively.
3.2. scr3559 RNA Expression Profiles (Northern Blotting)
scr3559 RNA levels were monitored throughout development for both the control C0 strain and the mutant C6S strain. Cells were cultivated in liquid NMMP medium and harvested after 12 h (early exponential phase of growth), 48 h (late exponential phase of growth) and 72 h of cultivation (stationary phase). No signal was detected in samples from the early exponential phase (not shown). A signal corresponding with pre-scr3559 RNA (260 nt) was detected only in the older cells of the C0 strain, whereas it is clearly seen in both developmental time points in the C6S over-expression strain (Figure 3). In both strains, the processed scr3559 RNA could only be detected during the exponential to stationary phase transition, when 6S RNA is expected to be active.
Figure 3.
Northern blot analysis of scr3559 RNA levels in C0 and C6S strain. The product at about 250 nt likely corresponds to the pre-scr3559 RNA. The processed scr3559 RNA (192 nt) could be seen only in 48 h-old cells of both C0 and C6S strains.
3.3. Phenotypic Analyses
After cultivation in NMMP medium with the selective antibiotic thiostrepton, the production of actinorhodin and undecylprodigiosin metabolites were measured and normalized per cell concentration. The dry weight of the cells was estimated after they were collected in spin columns (Qiagen), centrifuged and washed with ethanol. Elevated antibiotic production, actinorhodin (blue) and undecylprodigiosin (red) were repeatedly detected in the C6S overexpression strain, compared with the C0 control strain (Figure 4).
Figure 4.
Liquid culture phenotypes: (a) The C0 control (left) and C6S (right) strains after 72 h of cultivation in NMMP liquid medium. (b) Comparison of actinorhodin production in C0 and C6S strains; the y-axis indicates absorbance at A640 ×100 and normalized per cell concentration. The error bars represent a confidence interval from at least four independent biological replicates (α = 0.2). (c) Comparison of undecylprodigiosin production in C0 and C6S strains; the y-axis indicates absorbance at A530 × 100 and normalized per cell concentration. The error bars represent a confidence interval from at least three independent biological replicates (α = 0.2).
When cultivated on solid agar plates containing thiostrepton (R2YE, SMMS, MS), the C6S strains revealed differences in morphology (small colonies, aberrant mycelium formation, less biomass, and more rapid sporulation compared to the C0 control), and exhibited increased production of secondary metabolites (mainly blue actinorhodin) (Figure 5a). This observation was supported by the data collected using electron microscopy to compare the morphology of C6S and C0 control strains grown in the presence of thiostrepton. The pictures clearly show the accelerated development of the aerial mycelium for the C6S strain (Figure 5b).
Figure 5.
Solid culture phenotypes: (a) The C6S (left) and C0 control (right) strains after 120 h of cultivation on MS medium. (b) Electron-micrographs of mycelia from the C6S (left) and C0 (right) strains after 120 h of cultivation on solid MS medium.
When cultivated on solid MS plates with apramycin and a gradient of thiostrepton, actinorhodin was visibly over-produced by the C6S strain only in the areas with higher concentrations of thiostrepton. In this area, growth of the C6S strain was slower, its cell density was lower and colonies were tiny and grey, suggesting that vegetative growth may be suppressed, and sporulation may be accelerated.
Growth in the area that did not contain thiostrepton (i.e., the tipA promoter is not induced and scr3559 is not overexpressed) looked similar to that of the C0 control strain, which did not show any phenotypic differences on the same thiostrepton gradient on MS medium. When cultivated on ONA medium with an equivalent thiostrepton gradient, the C6S strain produced visibly more actinorhodin throughout the entire plate. Only in the area with the highest thiostrepton concentrations, actinorhodin was overproduced in both strains. (Figure 6). This supports our assertion that overexpressing scr3559 (in response to thiostrepton induction) leads to profound phenotypic changes.
Figure 6.
The C6S and C0 strains on MS and ONA medium with a linear concentration gradient of thiostrepton (0–25 μL mL−1 respectively to the blue wedge shown to the right of the plates) after 120 h of cultivation. The dashed line indicates where the thiostrepton gradient begins (most concentrated area is at the top of the image).
3.4. LC-MS Analysis of Other Metabolite Production
After both C6S and C0 strains had been cultivated for 48 h in R3 liquid medium, supernatants were subjected to LC-MS analysis. No qualitative changes were observed in the production of secondary metabolites, but quantitative differences were detected. Besides the already described increased production of actinorhodin and undecylprodigiosin, other metabolites were detected in both strains. These include germicidins (A, B), desferrioxamines (B, E, G1), and coelimycin P1.
3.4.1. Germicidins
The LC-MS data qualitatively confirmed the presence of germicidin A (tR = 6.48 min) and germicidin B (tR = 5.91 min). The acquired m/z 197.1193 corresponded to the [M + H]+ of germicidin A with a theoretical m/z 197.1178. Based on a comparison of the area under the curve (AUC), six times higher production of germicidin A was observed in C6S (AUCC6S = 1252) compared with the C0 strain (AUCC0 = 206) (Figure 7). Germicidin B was also produced at higher levels in the C6S strain as well, although its levels were not as strikingly enhanced relative to that of germicidin A (AUCC6S = 336 and AUCC0 = 90). The acquired m/z 183.1031 corresponded to the [M + H]+ of germicidin B with a theoretical m/z 183.1021.
Figure 7.
Extracted LC-MS chromatograms of germicidin A produced by S. coelicolor C6S and C0 after 48 h of cultivation in R3 medium.
3.4.2. Desferrioxaomines
Desferrioxamine B was detected at tR = 3.14 min. The acquired m/z 561.3614 corresponded to the [M + H]+ of desferrioxamine B with a theoretical m/z 561.3625. The production of this metabolite during the cultivation in R3 with glucose was higher in C6S (AUCC6S = 173) than in C0 (AUCC0 = 110) (Figure 8). A similar trend was seen for the production of desferrioxamine E (AUCC6S = 208 vs. AUCC0 = 139) and G1 (AUCC6S = 34 vs. AUCC0 = 21). Desferrioxamine E was detected at tR = 4.72 min. The acquired m/z 601.3546 corresponded to the [M + H]+ of desferrioxamine E with a theoretical m/z 601.3561. Desferrioxamine G1 was also detected (tR = 3.28; m/z 619.3663), although the differences between the C6S and C0 strains were subtle.
Figure 8.
Extracted LC-MS chromatograms of desferrioxamine B produced by S. coelicolor C6S and C0 after 48 h of cultivation in R3 medium.
3.4.3. Coelimycin P1
We also confirmed the presence of coelimycin P1 (tR = 7.48), an unusual polyketide alkaloid produced by S. coelicolor [30]. The acquired m/z 349.1222 corresponded to the [M + H]+ of coelimycin P1 with a theoretical m/z 349.1229. Traces of this substance were detected when culturing both strains in R3 liquid medium with glucose (AUCC6S = 21 vs. AUCC0 = 8) (Figure 9). However, when we used glycerol instead of glucose as an energy source in the R3 cultivation medium, the production of coelimycin was apparent only in the C6S strain (AUCC6S = 139).
Figure 9.
Extracted LC-MS chromatograms of coelimycin P1 produced by S. coelicolor C6S and C0 after 48 h of cultivation in R3 medium with glucose or glycerol.
3.5. Microarray Transcriptional Analysis
Microarray analysis was performed on C0 and C6S cells grown in liquid NMMP medium. Since previous expression analysis had shown higher levels of scr3559 RNA at later stages of growth, two stages of cell development were investigated: 72 h (younger cells), corresponding to early stationary phase (transition from exponential growth phase, when antibiotic production typically initiates) and 144 h (older cells), corresponding to late stationary stage. Genes that exhibited differential changes in expression are summarized in Table 2 and discussed below.
Table 2.
Color heat map represents the range of gene expression change in the C6S strain relative to the C0 strain from most down-regulated (dark purple) to most up-regulated (dark maroon) genes.
| Gene SCO Number | Average Differential Expression (C6S/C0) | Gene/Cosmid Name | Protein/Gene Cluster | |
|---|---|---|---|---|
| Young Cells (72 h) | Old Cells (144 h) | |||
| 185 | −2.71 | 3.66 | crtB/SCJ1.34 | putative geranyl pyrophosphate synthase/Isorenieratene |
| 186 | −0.15 | 1.85 | crtE/SCJ1.35 | putative phytoene dehydrogenase (putative secreted protein)/Isorenieratene |
| 187 | −0.82 | 2.53 | crtI/SCJ1.36 | putative phytoene synthase/Isorenieratene |
| 188 | −0.41 | 1.52 | crtV/SCJ1.37 | putative methylesterase/Isorenieratene |
| 189 | −0.84 | 1.14 | crtU/SCJ1.38c | putative dehydrogenase/Isorenieratene |
| 190 | 0.02 | 1.20 | crtT/SCJ12.02c | Isorenieratene |
| 191 | −0.76 | 1.11 | crtY/SCJ12.03c | Isorenieratene |
| 216 | −1.27 | 2.72 | narG2 | nitrate reductase alpha chain NarG2 |
| 217 | −1.61 | 2.69 | narH2 | nitrate reductase beta chain NarH2 |
| 379 | 1.49 | 1.05 | katA/EC 1.11.1.6 | catalase KatA |
| 380 | 0.91 | 2.10 | SCF62.06 | conserved hypothetical protein |
| 381 | 2.37 | 2.30 | SCF62.07 | putative glycosyl transferase |
| 382 | 3.14 | 0.82 | SCF62.08 | UDP-glucose/GDP-mannose family dehydrogenase |
| 383 | 2.24 | 1.66 | SCF62.09 | hypothetical protein |
| 384 | 2.01 | 1.58 | SCF62.10 | putative membrane protein |
| 385 | 1.74 | 1.23 | SCF62.11 | putative membrane protein |
| 409 | 1.77 | 1.14 | sapA/SCF51.08c | spore-associated protein precursor |
| 489 | −3.72 | −6.22 | SCF34.08c | conserved hypothetical protein/Siderophore coelichelin |
| 490 | −2.18 | −3.35 | SCF34.09c | putative esterase/Siderophore coelichelin |
| 491 | −1.57 | −3.33 | SCF34.10c | putative ABC transporter transmembrane protein/Siderophore coelichelin |
| 492 | −0.88 | −3.73 | SCF34.11c | putative peptide synthetase/Siderophore coelichelin |
| 493 | −1.66 | −4.03 | SCF34.12c | putative ABC-transporter transmembrane protein/Siderophore coelichelin |
| 494 | −2.85 | −4.16 | SCF34.13c | putative iron-siderophore binding lipoprotein/Siderophore coelichelin |
| 495 | −1.32 | −1.66 | SCF34.14c | putative iron-siderophore ABC-transporter ATP-binding protein/Siderophore coelichelin |
| 496 | 0.61 | −2.29 | SCF34.15c | putative iron-siderophore permease transmembrane protein/Siderophore coelichelin |
| 497 | −0.40 | −2.20 | SCF34.16c | putative iron-siderophore permease transmembrane protein/Siderophore coelichelin |
| 498 | −0.96 | −6.16 | SCF34.17c | putative peptide monooxygenase/Siderophore coelichelin |
| 499 | −2.28 | −4.08 | SCF34.18 | putative formyltransferase/Siderophore coelichelin |
| 895 | −0.57 | −0.25 | hrdC/SCM1.28c | RNA polymerase principal sigma factor HrdC |
| 1849 | −2.84 | −1.28 | cobN | cobalamin biosynthesis protein CobN |
| 2077 | −1.22 | 0.55 | divIVA/SC4A10.10c | DivIVA |
| 2084 | −2.10 | 0.74 | murG/SC4A10.17c | putative UDP-N-acetylglucosamine-N-acetylmuramyl-(pentapeptide) pyrophosphoryl-undecaprenol N-acetylglucosamine transferase MurG |
| 2431 | 1.15 | −0.88 | abfA/SCC24.02c | AbfA |
| 2465 | 0.98 | 0.31 | hrdA/SC7A8.04c | RNA polymerase principal sigma factor HrdA |
| 2779 | 1.86 | 0.99 | acdH/SCC105.10 | acyl-CoA dehydrogenase AcdH |
| 2780 | −1.17 | −2.95 | SCC105.11 | putative secreted protein/Desferrioxamines |
| 2781 | −1.12 | −1.70 | SCC105.12 | hypothetical protein/Desferrioxamines |
| 2782 | −0.07 | −3.94 | SCC105.13 | putative pyridoxal-dependent decarboxylase/Desferrioxamines |
| 2783 | −0.45 | −4.20 | SCC105.14 | putative monooxygenase/Desferrioxamines |
| 2784 | −0.61 | −4.81 | SCC105.15 | putative aceytltranferase/Desferrioxamines |
| 2785 | −1.29 | −4.54 | SCC105.16 | conserved hypothetical protein/Desferrioxamines |
| 3110 | −2.88 | −5.29 | SCE41.19c | putative ABC transport system integral membrane protein |
| 3111 | −4.77 | −5.37 | SCE41.20c | putative ABC transport system ATP-binding protein |
| 3202 | −2.35 | −2.27 | hrdD/SCE22.19c | RNA polymerase principal sigma factor HrdD |
| 3287 | 0.86 | −0.71 | SCE15.04 | putative serine/arginine rich protein AbeA |
| 3288 | 7.22 | −1.63 | SCE15.05 | putative integral membrane protein AbeB |
| 3289 | 5.77 | −1.64 | SCE15.06 | putative large membrane protein AbeC |
| 3290 | 8.07 | −1.80 | SCE15.07 | hypothetical protein AbeD |
| 3291 | 0.39 | 1.53 | SCE15.08 | putative regulatory protein AbeR SARP |
| 3322 | −2.02 | 1.16 | SCE68.20 | putative membrane protein, a SCO3558 homolog |
| 3323 | 3.90 | 2.51 | SCE68.21 | putative RNA polymerase sigma factor BldN |
| 3413 | 3.81 | 1.28 | tipA/SCE9.20 | transcriptional regulator TipA |
| 3558 | −2.38 | 0.90 | SCH5.21 | putative morphological differentiation-associated protein |
| 3559 | −2.45 | −0.08 | SCH5.22c | putative oxidoreductase |
| 3607 | −2.72 | −1.51 | SC66T3.18c | putative secreted protein |
| 3608 | −3.18 | −0.34 | SC66T3.19c | hypothetical protein |
| 4654 | −1.57 | 1.74 | rpoB/SCD82.26 | DNA-directed RNA polymerase beta chain RpoB |
| 4655 | −1.47 | 1.11 | rpoC/SCD82.27 | SCDDNA-directed RNA polymerase beta’ chain RpoC |
| 5069 | 0.40 | 0.40 | SCBAC20F6.12 | putative oxidoreductase/Actinorhodin |
| 5070 | 0.87 | 0.66 | SCBAC20F6.13c | hydroxylacyl-CoA dehydrogenase/Actinorhodin |
| 5071 | 1.92 | 2.55 | SCBAC20F6.14c | hydroxylacyl-CoA dehydrogenase/Actinorhodin |
| 5072 | 1.34 | 1.99 | SCBAC20F6.15 | hydroxylacyl-CoA dehydrogenase/Actinorhodin |
| 5073 | 0.74 | 2.12 | SCBAC20F6.16 | putative oxidoreductase/Actinorhodin |
| 5074 | 1.67 | 1.83 | SCBAC20F6.17 | putative dehydratase/Actinorhodin |
| 5075 | 0.92 | 2.07 | ORF4/SCBAC28G1.01 | putative oxidoreductase/Actinorhodin |
| 5076 | 0.67 | 0.24 | actVA1/SCBAC28G1 | integral membrane protein/Actinorhodin |
| 5077 | −0.09 | 1.19 | actVA2/SCBAC28G1 | hypothetical protein/Actinorhodin |
| 5078 | 1.65 | 0.86 | actVA3/SCBAC28G1 | hypothetical protein/Actinorhodin |
| 5079 | 2.62 | 0.31 | actVA4/SCBAC28G1 | conserved hypothetical protein/Actinorhodin |
| 5080 | 1.25 | −0.41 | actVA5/SCBAC28G1 | putative hydrolase/Actinorhodin |
| 5081 | 0.48 | 2.40 | actVA6/SCBAC28G1 | hypothetical protein/Actinorhodin |
| 5082 | −1.18 | 0.42 | actII-1/SCBAC28G1 | putative transcriptional regulatory protein/Actinorhodin |
| 5083 | −0.12 | −2.64 | actII-2/SCBAC28G1 | putative actinorhodin transporter/Actinorhodin |
| 5084 | 1.31 | −3.45 | actII-3/SCBAC28G1 | putative membrane protein/Actinorhodin |
| 5085 | −0.82 | 5.01 | actII-4/SCBAC28G1 | actinorhodin cluster activator protein/Actinorhodin |
| 5086 | 0.64 | 2.27 | actIII/SCBAC28G1 | ketoacyl reductase/Actinorhodin |
| 5087 | 0.76 | 1.90 | actI-1/SCBAC28G | actinorhodin polyketide beta-ketoacyl synthaselpha subunit/Actinorhodin |
| 5088 | 0.90 | 0.84 | actI-2/SCBAC28G | actinorhodin polyketide beta-ketoacyl synthaseeta subunit/Actinorhodin |
| 5089 | 0.67 | 2.72 | actI-3/SCBAC28G | actinorhodin polyketide synthase acyl carrierprotein/Actinorhodin |
| 5090 | 0.02 | 2.27 | actVII/SCBAC28G1 | actinorhodin polyketide synthase bifunctionalyclase/dehydratase/Actinorhodin |
| 5091 | −0.07 | 1.54 | actIV/SCBAC28G1.1 | cyclase/Actinorhodin |
| 5092 | 0.61 | 0.80 | actVB/SCBAC28G1.1 | actinorhodin polyketide putative dimerase/Actinorhodin |
| 5572 | −3.99 | 2.24 | rnc/SC7A1.16 | ribonuclease III/RNase III |
| 5621 | −1.70 | 3.75 | whiG/SC2E1.38 | RNA polymerase sigma factor WhiG |
| 5819 | 1.33 | 1.96 | whiH | Sporulation transcription factor WhiH |
| 5820 | −0.49 | 1.97 | hrdB/SC5B8.10 | major vegetative sigma factor HrdB |
| 5877 | 1.96 | 3.21 | redD | transcriptional regulator RedD/Prodiginines |
| 5878 | 1.34 | 0.94 | redX | polyketide synthase RedX/Prodiginines |
| 5879 | 0.33 | 0.32 | redW | acyl-coa dehydrogenase RedW/Prodiginines |
| 5880 | 0.09 | 3.34 | redY | RedY protein/Prodiginines |
| 5881 | −1.54 | 2.78 | redZ | response regulator/Prodiginines |
| 5882 | 0.61 | 0.02 | redV/SC3F7.02c | Prodiginines |
| 5883 | 0.79 | 0.87 | redU/SC3F7.03c | Prodiginines |
| 5884 | 1.41 | 0.09 | SC3F7.04c | hypothetical protein/Prodiginines |
| 5885 | 1.21 | −0.66 | SC3F7.05c | hypothetical protein/Prodiginines |
| 5886 | 1.68 | 2.31 | redR/SC3F7.06c | Prodiginines |
| 5887 | 2.60 | 0.20 | redQ/SC3F7.07c | Prodiginines |
| 5888 | 0.94 | −0.50 | redP/SC3F7.08 | 3-oxoacyl-[acyl-carrier-protein] synthase/Prodiginines |
| 5889 | 2.70 | 0.50 | redO/SC3F7.09 | hypothetical protein/Prodiginines |
| 5890 | 1.65 | 0.89 | redN/SC3F7.10 | putative 8-amino-7-oxononanoate synthase/Prodiginines |
| 5891 | 1.02 | −0.79 | redM/St3F7.11 | putative peptide synthase/Prodiginines |
| 5892 | 0.92 | −0.28 | redL/SC3F7.12 | polyketide synthase/Prodiginines |
| 5893 | 0.82 | 0.08 | redK/SC3F7.13 | oxidoreductase/Prodiginines |
| 5894 | 0.69 | 0.02 | redJ/SC3F7.14 | thioesterase/Prodiginines |
| 5895 | 1.24 | −0.04 | redI/SC3F7.15 | putative methyltransferase/Prodiginines |
| 5896 | 1.45 | 0.17 | SC10A5.01 | phosphoenolpyruvate-utilizing enzyme/Prodiginines |
| 5897 | 2.47 | 0.76 | redG/SC10A5.02 | Prodiginines |
| 5898 | 2.38 | 1.57 | redF/SC10A5.03 | Prodiginines |
| 6265 | −0.25 | 0.51 | scbR/SCAH10.30c | Gamma-butyrolactone binding protein |
| 6266 | 1.63 | 1.14 | scbA/SCAH10.31 | SCB1 butanolide synthase, an AfsA homolog/Gamma-butyrolactone |
| 6267 | −0.44 | 1.19 | SCAH10.32 | hypothetical protein, a BprA homolog |
| 6992 | 1.82 | 5.48 | absR1/SC8F11.18c | regulatory protein AbsR1 |
| 6993 | 1.31 | 2.10 | absR2/SC8F11.19 | regulatory protein AbsR2 |
| 7221 | −0.75 | 3.04 | SC2H12.20c | Gcs type III polyketide synthase |
4. Discussion
The regulatory capabilities of small RNAs have only been appreciated for the last 20 years or so. This lack of awareness is exemplified in work by Nishiyama et al. [31], where the authors created a Streptomyces azureus strain that overexpressed the BalA1 region of the chromosome (a 2.5-kb chromosomal DNA fragment). The resulting BalA1 strain formed little aerial hyphae and exhibited a capacity to overproduce secondary metabolites. The authors focused on the fact that the equivalent chromosomal region in the S. coelicolor genome contains two protein-coding genes: SCO3557 and SCO3558. They referred to SCO3558 as encoding a “morphological differentiation-associated protein”. Subsequent work [14,24,32] has revealed, however, that the SCO3558 gene is flanked by two sRNA-coding genes scr3558 (encoding 6C RNA) [24,33] and by the scr3559 (investigated here) (Figure 1). Expression of both scr3558 and scr3559 RNAs has been verified. Mutagenesis of the scr3558 gene had no effect on cell physiology (personal communication [34]), whereas deletion [16] and/or overproduction of the scr3559 RNA (our C6S strain) led to changes in morphological development and secondary metabolite production. The phenotypes in this study are reminiscent of those described for the S. azureus BalA1 strain, where the scr3559-equivalent RNA could be responsible for the observed change in cell physiology following overexpression of the sRNA region.
One may speculate that the BalA1 phenotype could be caused by increased expression of other gene product(s) from the BalA1 locus, including SCO3558 or SCO3559. The SCO3558 gene is a possible paralogue of the mmfP gene, which is located in a cluster of genes encoding enzymes responsible for the synthesis of the methylenomycin furans (MMFs) from the SCP1 plasmid of S. coelicolor [35]. These MMFs are freely diffusible signaling molecules that control the expression of the plasmid-encoded antibiotic methylenomycin. Nishiyama et al. also demonstrated that the S. azureus BalA1 strain induced its neighboring S. coelicolor A3(2) to produce the red antibiotic undecylprodigiosin early on in its life cycle. We therefore speculated that the scr3559 RNA in S. coelicolor may also contribute to the control of signaling molecule(s). However, we did not see any influence of the C6S strain on the development of the neighboring C0 strain, as was observed in the BalA1 strain. It is not yet clear whether either of the flanking protein-coding genes (SCO3558 and SCO3559), contribute to Streptomyces development, as their expression decreased in the C6S strain according to our microarray data.
The results presented here indicate that sRNAs contribute to the control of antibiotic production in Streptomyces species. Several pioneering studies on specific small RNAs expressed in Streptomyces have been published [36,37,38]. Subsequent bioinformatic approaches have predicted that tens of sRNA transcripts might be expressed during the developmental cycle of S. coelicolor [14,24,25,32,39,40]. The scr3559 RNA, whose pleiotropic phenotypic effects are described here, was first detected by Panek [14]. Further study revealed that the transcript’s secondary structure is reminiscent of the well-characterized 6S RNA [15]. Binding assays confirmed that scr3559 can form a complex with RNAP-HrdB and an analysis of its secondary structure validated these earlier predictions [16].
As we found here, two forms of scr3559 RNA are produced: a longer 260 nt-long molecule referred to here as pre-scr3559, and a shorter 192 nt-long “processed” form. 6S RNA processing has been studied in E. coli and other proteobacteria, where two precursor transcripts (transcribed from different promoters) are processed to give a mature 183 nt 6S RNA [41]. RNase E and its paralogue RNase G are required for this processing [41]. A similar situation has been noted in Bacillus thuringiensis, where two genes, ssrSA and ssrSB, are co-transcribed and processed by ribonucleases to give a functional 6S RNA [42]. It would be expected that equivalent RNases may contribute to the processing of the 6S RNA in S. coelicolor (Figure 2b); however, this has not yet been explored experimentally. It is also not known whether both precursor and processed-6S RNAs are functional, or whether functionality is confined to the processed form.
Interestingly, a deep sequencing analysis of S. coelicolor transcriptome detected a transcript antisense to the scr3559 RNA which is also expressed in the early stationary phase of cell development [32]. We believe that this could be a transcript equivalent to Ms1 RNA found in Mycobacterium smegmatis where it is positioned in the same antisense orientation [15,43]. Ms1 RNA accumulates in stationary phase and forms a 6S-like secondary structure [44]. Therefore, Ms1 RNA has been proposed to be the mycobacterial 6S RNA. It was however later demonstrated that Ms1 does not bind to the primary σ70-factor-RNAP complex, and instead forms a complex with the RNAP core that is devoid of the sigma factor [44]. This promotes increased sigma-free core RNA polymerase levels, leading to a reservoir of RNAP in stationary phase [45]. Further research is needed in order to elucidate the roles of both the 6S-like scr3559 RNA and its antisense Ms1-like transcript.
6S RNA levels are at their maximum during stationary phase in many bacteria [46]. In E. coli, 6S RNA levels increase up to 11 times in stationary phase compared to exponential phase [47], and the transcript effectively sequesters the majority of σ70 and upregulates σS synthesis [46,48,49]. This promotes optimal cell survival, promoting sigma factor switching by the transcriptional machinery and leading to different transcriptional outcomes. This allows the bacteria to better adapt to and survive various stress conditions including nutrient limitation, and prolongs cell viability when compared with 6S RNA-deficient strains [46].
Bacillus subtilis is slightly more complex, as it expresses two 6S RNAs: 6S-1 RNA and 6S-2 RNA. Whereas 6S-1 RNA exhibits a similar expression profile to the E. coli 6S RNA, 6S-2 RNA’s expression is steady throughout the cell cycle [13,50,51,52]. Interestingly, 6S-1 RNA impacts the timing of sporulation [53]. A strain of B. thuringiensis lacking 6S-1 RNA also exhibited a reduced capacity to survive stationary phase and was defective in spore formation [42]. 6S RNA has also been observed to mediate transition into a dormant state in Coxiella burnetii, an obligate intracellular pathogen. The cellular level of 6S RNA in this bacterium peaks after developmental differentiation into a spore-like small cell variant [54].
These findings are all consistent with our observations in Streptomyces. As we have shown, scr3559 RNA levels increase during the transition into stationary phase, and culminate with onset of antibiotic production. When scr3559 expression was induced by thiostrepton, the C6S strain was observed to promote rapid entry into stationary phase. On solid media, this resulted in the formation of very small, precociously sporulating colonies (Figure 5).
These observations correlated with our microarray analyses, where we observed increased transcript levels for genes whose products drive aerial hyphae development, septation and sporulation in the C6S strain. Although some streptomycete strains, like S. coelicolor, do not develop aerial mycelium and spores in liquid media, transcriptomic data suggest that gene expression in liquid and solid cultures are comparable [55]. A comparative transcriptomic study revealed that 86% of genes are expressed at the same level in both liquid and solid media, including genes involved in sporulation (bldN, sapA, and whiG, among others) [55].
The alternative BldN-sigma factor of RNAP is required for aerial mycelium formation and subsequent sporulation [56]. As our microarray data show, transcript levels of this developmental regulator in the C6S strain exhibited an almost four-fold increase in younger cells (72 h) and an approximate two and a half fold increase in older cultures (144 h) compared with the control strain C0.
Early stages of sporulation are regulated by WhiG, another alternative sigma factor of RNAP [57]. Its regulon members include whiH, which encodes a sporulation transcription factor [58,59,60]. WhiH is required for the process of aerial hyphae septation; only a few sporulation septa are formed in loosely coiled aerial hyphae when this GntR-family transcription factor is missing [58]. whiH also activates the expression of geoA, a gene encoding an enzyme responsible for the synthesis of the earthy volatile compound geosmin [61]. The expression of whiH and whiG genes was doubled and tripled, respectively, in the older C6S strain. Also upregulated in C6S was the expression of the spore-associated protein SapA-encoding gene, whose synthesis is also connected with the aerial hyphae development [62,63].
Morphological development during stationary phase is accompanied by increased secondary metabolism; this was even more active when high levels of scr3559 RNA were produced. One explanation for this could be through elevated levels of the γ-butyrolactone bacterial hormones. These molecules are responsible for cell signaling, coordinating morphological changes, and triggering the onset of secondary metabolism during stationary phase [64,65]. The synthesis of the S. coelicolor butanolide (SCB; an equivalent molecule to A-factor in S. griseus) is directed by the γ-butyrolactone synthase ScbA [66]. SCB is sensed by the receptor protein ScbR, whose repression of biosynthetic gene clusters is then relieved. Our microarray data show that in the young C6S strain, expression of scbA is upregulated, while expression of scbR is reduced. Two other genetic loci, whose expression is known to activate antibiotic production in S. coelicolor (the Abe cluster [67] and AbsR [68]), were also upregulated in the younger C6S strain. These activation events may contribute to the increased production of antibiotics.
Other than actinorhodin, the C6S strain produced the undecylprodigiosin (red) antibiotic earlier in its life cycle and in higher concentrations than the control C0 strain. Prodiginines are membrane damaging molecules that are produced inside the substrate mycelia cells in nutrient-deficient conditions. Lacking any self-resistance gene, they may contribute to a programmed cell death process that supports aerial hyphae development [69]. The “red” biosynthetic pathway is activated by the RedD regulator, whose gene expression is upregulated (doubled to tripled) during the development of the C6S strain. This occurs in concert with reduced growth of vegetative hyphae of the C6S strain observed here (Figure 5).
Other upregulated secondary metabolite gene clusters in the C6S strain include crtEIBV and crtYTU (in older cells), which are associated with the carotenoid isorenieratene synthesis pathway [70] and the Gcs type III polyketide (germicidins) [71], respectively. The expression of the Gcs gene SCO7221 was tripled in older C6S cells, in accordance with the elevated germicidin levels observed in our LC-MS analysis (Figure 7). Germicidin A inhibits not only spore germination, but also vegetative hyphae elongation [72]. Thus, the germicidins may therefore contribute—possibly in association with the prodiginines—to the sporulation process supported by the scr3559 RNA.
5. Conclusions
The phenotypic observations presented here imply that scr3559 RNA plays a central role in the developmental control mechanisms of Streptomyces bacteria. The similarities shared by scr3559 RNA and bacterial 6S RNAs [16] may explain its pleiotropic effects on development and secondary metabolism. 6S RNA in Streptomyces may function to sequester exponential phase-specific HrdB-RNAP in order to effectively promote entry into stationary phase, leading to the formation of spores. As this development is accompanied by increased activity of secondary metabolism, the 6S RNA role also appears to include an impact on antibiotic production, given the elevated levels observed in the C6S over-expression strain.
Acknowledgments
The authors are very grateful to Oldřich Benada and to Olga Kofroňová for electron microscopic pictures. We thank Karel Mikulík in memoriam for his lifelong research work and training of the next generation of scientists.
Author Contributions
J.B. conceptualized the project, performed the experiments, analyzed the data, and wrote the original manuscript; A.M. performed cultivations and antibiotic production measurements; D.Š. performed northern blot experiments; M.E. assisted in the design and preparation of experiments, data interpretation, and writing the manuscript; M.Č. performed LC-MS measurements and data analyses. All of the authors proofread the manuscript. All authors have read and agreed to the published version of the manuscript.
Funding
Project No.: UJEP-SGS-2020-53-002-2 was supported by grant within student grant competition at UJEP, Jan Evangelista Purkyně University in Ústí nad Labem. This research was funded by Charles University, grant PROGRES Q25/LF1 and SVV260520, and by an NSERC Discovery grant (No. 04681) to M.E.
Institutional Review Board Statement
Not applicable.
Informed Consent Statement
Not applicable.
Data Availability Statement
Not applicable.
Conflicts of Interest
The authors declare no conflict of interest.
Footnotes
Publisher’s Note: MDPI stays neutral with regard to jurisdictional claims in published maps and institutional affiliations.
References
- 1.Kelemen G.H., Buttner M.J. Initiation of aerial mycelium formation in Streptomyces. Curr. Opin. Microbiol. 1998;1:656–662. doi: 10.1016/S1369-5274(98)80111-2. [DOI] [PubMed] [Google Scholar]
- 2.Flardh K., Buttner M.J. Streptomyces morphogenetics: Dissecting differentiation in a filamentous bacterium. Nat. Rev. Microbiol. 2009;7:36–49. doi: 10.1038/nrmicro1968. [DOI] [PubMed] [Google Scholar]
- 3.Flardh K., Richards D.M., Hempel A.M., Howard M., Buttner M.J. Regulation of apical growth and hyphal branching in Streptomyces. Curr. Opin. Microbiol. 2012;15:737–743. doi: 10.1016/j.mib.2012.10.012. [DOI] [PubMed] [Google Scholar]
- 4.Bobek J., Strakova E., Zikova A., Vohradsky J. Changes in activity of metabolic and regulatory pathways during germination of S. coelicolor. BMC Genomics. 2014;15:1173. doi: 10.1186/1471-2164-15-1173. [DOI] [PMC free article] [PubMed] [Google Scholar]
- 5.McCormick J.R., Flardh K. Signals and regulators that govern Streptomyces development. FEMS Microbiol. Rev. 2012;36:206–231. doi: 10.1111/j.1574-6976.2011.00317.x. [DOI] [PMC free article] [PubMed] [Google Scholar]
- 6.Hopwood D.A. Forty years of genetics with Streptomyces: From in vivo through in vitro to in silico. Pt 9Microbiology. 1999;145:2183–2202. doi: 10.1099/00221287-145-9-2183. [DOI] [PubMed] [Google Scholar]
- 7.Claessen D., de Jong W., Dijkhuizen L., Wosten H.A. Regulation of Streptomyces development: Reach for the sky! Trends Microbiol. 2006;14:313–319. doi: 10.1016/j.tim.2006.05.008. [DOI] [PubMed] [Google Scholar]
- 8.Majdalani N., Vanderpool C.K., Gottesman S. Bacterial small RNA regulators. Crit. Rev. Biochem. Mol. Biol. 2005;40:93–113. doi: 10.1080/10409230590918702. [DOI] [PubMed] [Google Scholar]
- 9.Wassarman K.M. 6S RNA, a global regulator of transcription. Microbiol. Spectr. 2018;6:355–367. doi: 10.1128/microbiolspec.RWR-0019-2018. [DOI] [PMC free article] [PubMed] [Google Scholar]
- 10.Gildehaus N., Neusser T., Wurm R., Wagner R. Studies on the function of the riboregulator 6S RNA from E. coli: RNA polymerase binding, inhibition of in vitro transcription and synthesis of RNA-directed de novo transcripts. Nucleic Acids Res. 2007;35:1885–1896. doi: 10.1093/nar/gkm085. [DOI] [PMC free article] [PubMed] [Google Scholar]
- 11.Wassarman K.M., Saecker R.M. Synthesis-mediated release of a small RNA inhibitor of RNA polymerase. Science. 2006;314:1601–1603. doi: 10.1126/science.1134830. [DOI] [PubMed] [Google Scholar]
- 12.Willkomm D.K., Minnerup J., Huttenhofer A., Hartmann R.K. Experimental rnomics in aquifex aeolicus: Identification of small non-coding RNAs and the putative 6S RNA homolog. Nucleic Acids Res. 2005;33:1949–1960. doi: 10.1093/nar/gki334. [DOI] [PMC free article] [PubMed] [Google Scholar]
- 13.Barrick J.E., Sudarsan N., Weinberg Z., Ruzzo W.L., Breaker R.R. 6S RNA is a widespread regulator of eubacterial RNA polymerase that resembles an open promoter. RNA. 2005;11:774–784. doi: 10.1261/rna.7286705. [DOI] [PMC free article] [PubMed] [Google Scholar]
- 14.Panek J., Bobek J., Mikulik K., Basler M., Vohradsky J. Biocomputational prediction of small non-coding RNAs in Streptomyces. BMC Genomics. 2008;9:217. doi: 10.1186/1471-2164-9-217. [DOI] [PMC free article] [PubMed] [Google Scholar]
- 15.Panek J., Krasny L., Bobek J., Jezkova E., Korelusova J., Vohradsky J. The suboptimal structures find the optimal RNAs: Homology search for bacterial non-coding RNAs using suboptimal RNA structures. Nucleic Acids Res. 2011;39:3418–3426. doi: 10.1093/nar/gkq1186. [DOI] [PMC free article] [PubMed] [Google Scholar]
- 16.Mikulik K., Bobek J., Zidkova J., Felsberg J. 6S RNA modulates growth and antibiotic production in Streptomyces coelicolor. Appl. Microbiol. Biotechnol. 2014;98:7185–7197. doi: 10.1007/s00253-014-5806-4. [DOI] [PubMed] [Google Scholar]
- 17.Sambrook J.R., Russell D.W. Molecular Cloning: A Laboratory Manual. 3rd ed. Cold Spring Harbor Laboratory Press; Cold Spring Harbor, NY, USA: 2001. p. A2.2. [Google Scholar]
- 18.Kieser T., Bibb M.J., Buttner M.J., Chater K.F., Hopwood D.A. Practical Streptomyces Genetics. 2nd ed. John Innes Foundation; Norwich, UK: 2000. [Google Scholar]
- 19.Shima J., Hesketh A., Okamoto S., Kawamoto S., Ochi K. Induction of actinorhodin production by rpsl (encoding ribosomal protein s12) mutations that confer streptomycin resistance in Streptomyces lividans and Streptomyces coelicolor A3(2) J. Bacteriol. 1996;178:7276–7284. doi: 10.1128/jb.178.24.7276-7284.1996. [DOI] [PMC free article] [PubMed] [Google Scholar]
- 20.MacNeil D.J., Occi J.L., Gewain K.M., MacNeil T., Gibbons P.H., Ruby C.L., Danis S.J. Complex organization of the Streptomyces avermitilis genes encoding the avermectin polyketide synthase. Gene. 1992;115:119–125. doi: 10.1016/0378-1119(92)90549-5. [DOI] [PubMed] [Google Scholar]
- 21.Janssen G.R., Bibb M.J. Derivatives of pUC18 that have BglII sites flanking a modified multiple cloning site and that retain the ability to identify recombinant clones by visual screening of Escherichia coli colonies. Gene. 1993;124:133–134. doi: 10.1016/0378-1119(93)90774-W. [DOI] [PubMed] [Google Scholar]
- 22.Wilkinson C.J., Hughes-Thomas Z.A., Martin C.J., Bohm I., Mironenko T., Deacon M., Wheatcroft M., Wirtz G., Staunton J., Leadlay P.F. Increasing the efficiency of heterologous promoters in actinomycetes. J. Mol. Microbiol. Biotechnol. 2002;4:417–426. [PubMed] [Google Scholar]
- 23.Redenbach M., Kieser H.M., Denapaite D., Eichner A., Cullum J., Kinashi H., Hopwood D.A. A set of ordered cosmids and a detailed genetic and physical map for the 8 Mb Streptomyces coelicolor A3(2) chromosome. Mol. Microbiol. 1996;21:77–96. doi: 10.1046/j.1365-2958.1996.6191336.x. [DOI] [PubMed] [Google Scholar]
- 24.Swiercz J.P., Bobek J., Haiser H.J., Di Berardo C., Tjaden B., Elliot M.A. Small non-coding RNAs in Streptomyces coelicolor. Nucleic Acids Res. 2008;36:7240–7251. doi: 10.1093/nar/gkn898. [DOI] [PMC free article] [PubMed] [Google Scholar]
- 25.Setinova D., Smidova K., Pohl P., Music I., Bobek J. RNase III-binding-mRNAs revealed novel complementary transcripts in Streptomyces. Front. Microbiol. 2017;8:2693. doi: 10.3389/fmicb.2017.02693. [DOI] [PMC free article] [PubMed] [Google Scholar]
- 26.Kang S.G., Jin W., Bibb M., Lee K.J. Actinorhodin and undecylprodigiosin production in wild-type and relA mutant strains of Streptomyces coelicolor A3(2) grown in continuous culture. FEMS Microbiol. Lett. 1998;168:221–226. doi: 10.1111/j.1574-6968.1998.tb13277.x. [DOI] [PubMed] [Google Scholar]
- 27.Cihak M., Kamenik Z., Smidova K., Bergman N., Benada O., Kofronova O., Petrickova K., Bobek J. Secondary metabolites produced during the germination of Streptomyces coelicolor. Front. Microbiol. 2017;8:2495. doi: 10.3389/fmicb.2017.02495. [DOI] [PMC free article] [PubMed] [Google Scholar]
- 28.Kamenik Z., Hadacek F., Mareckova M., Ulanova D., Kopecky J., Chobot V., Plhackova K., Olsovska J. Ultra-high-performance liquid chromatography fingerprinting method for chemical screening of metabolites in cultivation broth. J. Chromatogr. A. 2010;1217:8016–8025. doi: 10.1016/j.chroma.2010.08.031. [DOI] [PubMed] [Google Scholar]
- 29.Gruber A.R., Lorenz R., Bernhart S.H., Neubock R., Hofacker I.L. The Vienna RNA websuite. Nucleic Acids Res. 2008;36:W70–W74. doi: 10.1093/nar/gkn188. [DOI] [PMC free article] [PubMed] [Google Scholar]
- 30.Gomez-Escribano J.P., Bibb M.J. Streptomyces coelicolor as an expression host for heterologous gene clusters. Methods Enzymol. 2012;517:279–300. doi: 10.1016/B978-0-12-404634-4.00014-0. [DOI] [PubMed] [Google Scholar]
- 31.Nishiyama T., Sakemi H., Sumi H., Tokunaga S., Doi K., Ogata S. A chromosomal locus encoding a phosphoserine phosphatase- and a truncated mind-like protein affects differentiation in Streptomyces azureus ATCC14921. FEMS Microbiol. Lett. 2000;190:133–139. doi: 10.1111/j.1574-6968.2000.tb09275.x. [DOI] [PubMed] [Google Scholar]
- 32.Vockenhuber M.P., Sharma C.M., Statt M.G., Schmidt D., Xu Z., Dietrich S., Liesegang H., Mathews D.H., Suess B. Deep sequencing-based identification of small non-coding RNAs in Streptomyces coelicolor. RNA Biol. 2011;8:468–477. doi: 10.4161/rna.8.3.14421. [DOI] [PMC free article] [PubMed] [Google Scholar]
- 33.Mai J., Rao C., Watt J., Sun X., Lin C., Zhang L., Liu J. Mycobacterium tuberculosis 6C sRNA binds multiple mRNA targets via C-rich loops independent of RNA chaperones. Nucleic Acids Res. 2019;47:4292–4307. doi: 10.1093/nar/gkz149. [DOI] [PMC free article] [PubMed] [Google Scholar]
- 34.Swiercz J.P., Elliot M.A. McMaster University, Hamilton, ON, Canada. Unpublished work. 2009 [Google Scholar]
- 35.Corre C., Song L., O’Rourke S., Chater K.F., Challis G.L. 2-alkyl-4-hydroxymethylfuran-3-carboxylic acids, antibiotic production inducers discovered by Streptomyces coelicolor genome mining. Proc. Natl. Acad. Sci. USA. 2008;105:17510–17515. doi: 10.1073/pnas.0805530105. [DOI] [PMC free article] [PubMed] [Google Scholar]
- 36.Paleckova P., Bobek J., Felsberg J., Mikulik K. Activity of translation system and abundance of tmRNA during development of Streptomyces aureofaciens producing tetracycline. Folia Microbiol. 2006;51:517–524. doi: 10.1007/BF02931615. [DOI] [PubMed] [Google Scholar]
- 37.Mikulik K., Paleckova P., Felsberg J., Bobek J., Zidkova J., Halada P. SsrA genes of streptomycetes and association of proteins to the tmRNA during development and cellular differentiation. Proteomics. 2008;8:1429–1441. doi: 10.1002/pmic.200700560. [DOI] [PubMed] [Google Scholar]
- 38.Engel F., Ossipova E., Jakobsson P.J., Vockenhuber M.P., Suess B. sRNA scr5239 involved in feedback loop regulation of Streptomyces coelicolor central metabolism. Front. Microbiol. 2019;10:3121. doi: 10.3389/fmicb.2019.03121. [DOI] [PMC free article] [PubMed] [Google Scholar]
- 39.Moody M.J., Young R.A., Jones S.E., Elliot M.A. Comparative analysis of non-coding RNAs in the antibiotic-producing Streptomyces bacteria. BMC Genomics. 2013;14:558. doi: 10.1186/1471-2164-14-558. [DOI] [PMC free article] [PubMed] [Google Scholar]
- 40.Yi J.S., Kim M.W., Kim M., Jeong Y., Kim E.J., Cho B.K., Kim B.G. A novel approach for gene expression optimization through native promoter and 5′ UTR combinations based on RNA-seq, Ribo-seq, and TSS-seq of Streptomyces coelicolor. ACS Synth. Biol. 2017;6:555–565. doi: 10.1021/acssynbio.6b00263. [DOI] [PubMed] [Google Scholar]
- 41.Kim K.S., Lee Y. Regulation of 6S RNA biogenesis by switching utilization of both sigma factors and endoribonucleases. Nucleic Acids Res. 2004;32:6057–6068. doi: 10.1093/nar/gkh939. [DOI] [PMC free article] [PubMed] [Google Scholar]
- 42.Li Z., Zhu L., Yu Z., Liu L., Chou S.H., Wang J., He J. 6S-1 RNA contributes to sporulation and parasporal crystal formation in Bacillus thuringiensis. Front. Microbiol. 2020;11:604458. doi: 10.3389/fmicb.2020.604458. [DOI] [PMC free article] [PubMed] [Google Scholar]
- 43.Behra P.R.K., Pettersson B.M.F., Das S., Dasgupta S., Kirsebom L.A. Comparative genomics of Mycobacterium mucogenicum and Mycobacterium neoaurum clade members emphasizing tRNA and non-coding RNA. BMC Evol. Biol. 2019;19:124. doi: 10.1186/s12862-019-1447-7. [DOI] [PMC free article] [PubMed] [Google Scholar]
- 44.Hnilicova J., Jirat Matejckova J., Sikova M., Pospisil J., Halada P., Panek J., Krasny L. Ms1, a novel sRNA interacting with the RNA polymerase core in mycobacteria. Nucleic Acids Res. 2014;42:11763–11776. doi: 10.1093/nar/gku793. [DOI] [PMC free article] [PubMed] [Google Scholar]
- 45.Sikova M., Janouskova M., Ramaniuk O., Palenikova P., Pospisil J., Bartl P., Suder A., Pajer P., Kubickova P., Pavlis O., et al. Ms1 RNA increases the amount of RNA polymerase in Mycobacterium smegmatis. Mol. Microbiol. 2019;111:354–372. doi: 10.1111/mmi.14159. [DOI] [PubMed] [Google Scholar]
- 46.Trotochaud A.E., Wassarman K.M. 6S RNA function enhances long-term cell survival. J. Bacteriol. 2004;186:4978–4985. doi: 10.1128/JB.186.15.4978-4985.2004. [DOI] [PMC free article] [PubMed] [Google Scholar]
- 47.Wassarman K.M., Storz G. 6S RNA regulates E. coli RNA polymerase activity. Cell. 2000;101:613–623. doi: 10.1016/S0092-8674(00)80873-9. [DOI] [PubMed] [Google Scholar]
- 48.Cavanagh A.T., Klocko A.D., Liu X., Wassarman K.M. Promoter specificity for 6S RNA regulation of transcription is determined by core promoter sequences and competition for region 4.2 of sigma70. Mol. Microbiol. 2008;67:1242–1256. doi: 10.1111/j.1365-2958.2008.06117.x. [DOI] [PubMed] [Google Scholar]
- 49.Neusser T., Polen T., Geissen R., Wagner R. Depletion of the non-coding regulatory 6S RNA in E. coli causes a surprising reduction in the expression of the translation machinery. BMC Genomics. 2010;11:165. doi: 10.1186/1471-2164-11-165. [DOI] [PMC free article] [PubMed] [Google Scholar]
- 50.Ando Y., Asari S., Suzuma S., Yamane K., Nakamura K. Expression of a small RNA, bs203 RNA, from the yocI-yocJ intergenic region of Bacillus subtilis genome. FEMS Microbiol. Lett. 2002;207:29–33. doi: 10.1016/S0378-1097(01)00551-1. [DOI] [PubMed] [Google Scholar]
- 51.Beckmann B.M., Burenina O.Y., Hoch P.G., Kubareva E.A., Sharma C.M., Hartmann R.K. In vivo and in vitro analysis of 6S RNA-templated short transcripts in Bacillus subtilis. RNA Biol. 2011;8:839–849. doi: 10.4161/rna.8.5.16151. [DOI] [PubMed] [Google Scholar]
- 52.Suzuma S., Asari S., Bunai K., Yoshino K., Ando Y., Kakeshita H., Fujita M., Nakamura K., Yamane K. Identification and characterization of novel small RNAs in the aspS-yrvM intergenic region of the Bacillus subtilis genome. Microbiology. 2002;148:2591–2598. doi: 10.1099/00221287-148-8-2591. [DOI] [PubMed] [Google Scholar]
- 53.Cavanagh A.T., Wassarman K.M. 6S-1 RNA function leads to a delay in sporulation in Bacillus subtilis. J. Bacteriol. 2013;195:2079–2086. doi: 10.1128/JB.00050-13. [DOI] [PMC free article] [PubMed] [Google Scholar]
- 54.Warrier I., Hicks L.D., Battisti J.M., Raghavan R., Minnick M.F. Identification of novel small RNAs and characterization of the 6S RNA of Coxiella burnetii. PLoS ONE. 2014;9:e100147. doi: 10.1371/journal.pone.0100147. [DOI] [PMC free article] [PubMed] [Google Scholar]
- 55.Yague P., Rodriguez-Garcia A., Lopez-Garcia M.T., Rioseras B., Martin J.F., Sanchez J., Manteca A. Transcriptomic analysis of liquid non-sporulating Streptomyces coelicolor cultures demonstrates the existence of a complex differentiation comparable to that occurring in solid sporulating cultures. PLoS ONE. 2014;9:e86296. doi: 10.1371/journal.pone.0086296. [DOI] [PMC free article] [PubMed] [Google Scholar]
- 56.Bibb M.J., Molle V., Buttner M.J. Sigma(BldN), an extracytoplasmic function RNA polymerase sigma factor required for aerial mycelium formation in Streptomyces coelicolor A3(2) J. Bacteriol. 2000;182:4606–4616. doi: 10.1128/JB.182.16.4606-4616.2000. [DOI] [PMC free article] [PubMed] [Google Scholar]
- 57.Mendez C., Chater K.F. Cloning of whiG, a gene critical for sporulation of Streptomyces coelicolor A3(2) J. Bacteriol. 1987;169:5715–5720. doi: 10.1128/jb.169.12.5715-5720.1987. [DOI] [PMC free article] [PubMed] [Google Scholar]
- 58.Flardh K., Findlay K.C., Chater K.F. Association of early sporulation genes with suggested developmental decision points in Streptomyces coelicolor A3(2) Pt 9Microbiology. 1999;145:2229–2243. doi: 10.1099/00221287-145-9-2229. [DOI] [PubMed] [Google Scholar]
- 59.Chater K.F. Multilevel regulation of Streptomyces differentiation. Trends Genet. 1989;5:372–377. doi: 10.1016/0168-9525(89)90172-8. [DOI] [PubMed] [Google Scholar]
- 60.Ryding N.J., Kelemen G.H., Whatling C.A., Flardh K., Buttner M.J., Chater K.F. A developmentally regulated gene encoding a repressor-like protein is essential for sporulation in Streptomyces coelicolor A3(2) Mol. Microbiol. 1998;29:343–357. doi: 10.1046/j.1365-2958.1998.00939.x. [DOI] [PubMed] [Google Scholar]
- 61.Becher P.G., Verschut V., Bibb M.J., Bush M.J., Molnar B.P., Barane E., Al-Bassam M.M., Chandra G., Song L., Challis G.L., et al. Developmentally regulated volatiles geosmin and 2-methylisoborneol attract a soil arthropod to Streptomyces bacteria promoting spore dispersal. Nat. Microbiol. 2020;5:821–829. doi: 10.1038/s41564-020-0697-x. [DOI] [PubMed] [Google Scholar]
- 62.Guijarro J., Santamaria R., Schauer A., Losick R. Promoter determining the timing and spatial localization of transcription of a cloned Streptomyces coelicolor gene encoding a spore-associated polypeptide. J. Bacteriol. 1988;170:1895–1901. doi: 10.1128/jb.170.4.1895-1901.1988. [DOI] [PMC free article] [PubMed] [Google Scholar]
- 63.Willey J., Santamaria R., Guijarro J., Geistlich M., Losick R. Extracellular complementation of a developmental mutation implicates a small sporulation protein in aerial mycelium formation by S. coelicolor. Cell. 1991;65:641–650. doi: 10.1016/0092-8674(91)90096-H. [DOI] [PubMed] [Google Scholar]
- 64.Khokhlov A.S., Tovarova I.I., Borisova L.N., Pliner S.A., Shevchenko L.N., Kornitskaia E., Ivkina N.S., Rapoport I.A. [The a-factor, responsible for streptomycin biosynthesis by mutant strains of actinomyces streptomycini] Dokl. Akad. Nauk. SSSR. 1967;177:232–235. [PubMed] [Google Scholar]
- 65.Takano E. Gamma-butyrolactones: Streptomyces signalling molecules regulating antibiotic production and differentiation. Curr. Opin. Microbiol. 2006;9:287–294. doi: 10.1016/j.mib.2006.04.003. [DOI] [PubMed] [Google Scholar]
- 66.Kato J.Y., Funa N., Watanabe H., Ohnishi Y., Horinouchi S. Biosynthesis of gamma-butyrolactone autoregulators that switch on secondary metabolism and morphological development in Streptomyces. Proc. Natl. Acad. Sci. USA. 2007;104:2378–2383. doi: 10.1073/pnas.0607472104. [DOI] [PMC free article] [PubMed] [Google Scholar]
- 67.Hindra , Pak P., Elliot M.A. Regulation of a novel gene cluster involved in secondary metabolite production in Streptomyces coelicolor. J. Bacteriol. 2010;192:4973–4982. doi: 10.1128/JB.00681-10. [DOI] [PMC free article] [PubMed] [Google Scholar]
- 68.Park U.M., Suh J.W., Hong S.K. Genetic analysis of absR, a new abs locus of Streptomyces coelicolor. J. Microbiol. Biotechnol. 2000;10:169–175. [Google Scholar]
- 69.Tenconi E., Traxler M.F., Hoebreck C., van Wezel G.P., Rigali S. Production of prodiginines is part of a programmed cell death process in Streptomyces coelicolor. Front. Microbiol. 2018;9:1742. doi: 10.3389/fmicb.2018.01742. [DOI] [PMC free article] [PubMed] [Google Scholar]
- 70.Takano H., Obitsu S., Beppu T., Ueda K. Light-induced carotenogenesis in Streptomyces coelicolor A3(2): Identification of an extracytoplasmic function sigma factor that directs photodependent transcription of the carotenoid biosynthesis gene cluster. J. Bacteriol. 2005;187:1825–1832. doi: 10.1128/JB.187.5.1825-1832.2005. [DOI] [PMC free article] [PubMed] [Google Scholar]
- 71.Song L., Barona-Gomez F., Corre C., Xiang L., Udwary D.W., Austin M.B., Noel J.P., Moore B.S., Challis G.L. Type III polyketide synthase beta-ketoacyl-acp starter unit and ethylmalonyl-coa extender unit selectivity discovered by Streptomyces coelicolor genome mining. J. Am. Chem. Soc. 2006;128:14754–14755. doi: 10.1021/ja065247w. [DOI] [PMC free article] [PubMed] [Google Scholar]
- 72.Aoki Y., Matsumoto D., Kawaide H., Natsume M. Physiological role of germicidins in spore germination and hyphal elongation in Streptomyces coelicolor A3(2) J. Antibiot. 2011;64:607–611. doi: 10.1038/ja.2011.59. [DOI] [PubMed] [Google Scholar]
Associated Data
This section collects any data citations, data availability statements, or supplementary materials included in this article.
Data Availability Statement
Not applicable.